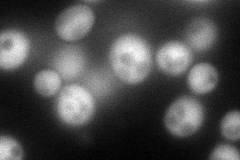
YCL034W
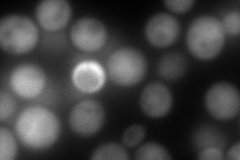
YCL034W
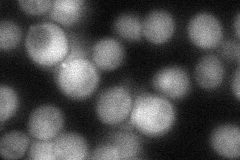
YCL034W
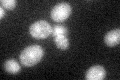
YCL034W

View description
Protein of unknown function; binds Las17p, which is a homolog of human Wiskott-Aldrich Syndrome protein involved in actin patch assembly and actin polymerization; may mediate disassembly of the Pan1 complex from the endocytic coat
Localization:
Intensity:
Fold change:
Significance:
-
C’ GFP library in SD

cytosol26.78 -
N' NOP1pr-GFP in SD
cytosol118.479 -
N' TEF2pr-mCherry in SD
cytosol,nucleus217.98 -
N' NATIVEpr-GFP in SD
cytosol54.0476 -
N' TEF2pr-VC and Cyto-VN in SD

cytosol57.7214 -
C’ GFP library in SD+DTT

cytosol32.031.19No -
C’ GFP library in SD+H2O2

cytosolN/AN/ANo -
C’ GFP library in Starvation Media
cytosol50.81.89Yes -
C’ GFP library on the background of Pup2-DaMP

cytosol -
C’ GFP library on the background of CCT mutant

cytosol24.85420.927734No
